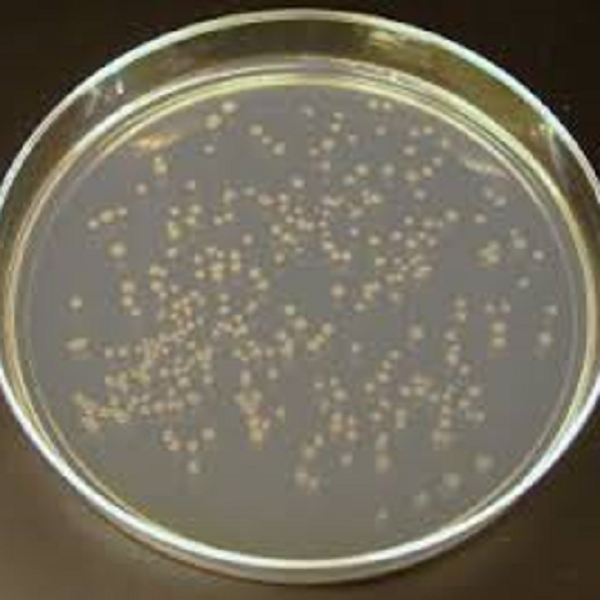

محیط کشت پپتون سالت (PEPTONE SALT) کیولب
0
0
PEPTONE SALT, Culture Media, Quelab
محیط کشت
.
محیط کشت براث
.
محیط کشت کیولب
.
مواد زیستی